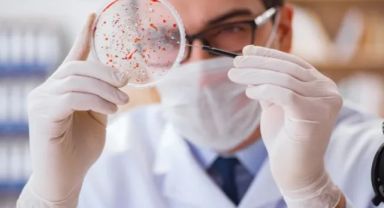
30 yıl sonra yeniden hortladı, Avrupa alarma geçti: Veba laboratuardan mı yayıldı?

İzmir Metro AŞ, uluslararası alanda önemli bir görev üstlendi. Dünya genelinde toplu taşıma ve sürdürülebilir kentsel hareketlilik konularında çalışan en büyük küresel ağlardan biri olan Uluslararası Toplu Taşıma Birliği’nin (UITP) üst düzey karar organlarından olan Politika Kurulu’nun ülke temsilciğine İzmir Metro AŞ Genel Müdürü A. Sinan Karakuzu seçildi. İzmir ulaşımının ana damarlarından olan, her gün binlerce İzmirlinin kullandığı İzmir Metro AŞ’ye uluslararası alanda da ülkemizi temsil görevi verildi. Sürdürülebilir ulaşım politikaları oluşturan, yeni gelişen teknolojiler ve kentsel hareketlilik eğilimlerine yanıt veren, üyelerin görüşlerini yansıtarak uluslararası platformda temsil sağlayan Uluslararası Toplu Taşıma Birliği’nin (UITP) üst düzey karar organlarından Politika Kurulu’nun ülke temsilciğine İzmir Metro AŞ Genel Müdürü A. Sinan Karakuzu seçildi. Uluslararası ulaşım modellerinin fikir alışverişiyle yayıldığı Uluslararası Toplu Taşıma Birliği’ne katılımla beraber her kıtadan yeni modeller incelenebilecek. Ülkeler arası proje alışverişi de yapılabilecek. Farklı kıtalardan ülkeler yer alıyorPolitika Kurulu, UITP'nin toplu taşıma ile ilgili küresel stratejik politikalarını ve duruşunu belirliyor. Farklı kıtalardan ülkelerin ve çeşitli ulaşım modlarından (metro, otobüs, tramvay, deniz taşımacılığı vb.) gelen üyeler bu kurulda temsil ediliyor. Böylece çok sesli, dengeli ve kapsayıcı bir karar yapısı oluşuyor. “Dünya markası haline getirmek için çalışmalarımıza devam edeceğiz”İzmir Metro AŞ Genel Müdürü Sinan Karakuzu, UITP’nin Politika Kurulu’nda Türkiye’yi temsilen sandalye sahibi olmasının önemine vurgu yaparak, “İzmir Metro AŞ olarak UITP içinde daha aktif görev alıp, dünyadaki benzer işletmelerin tecrübelerinden yola çıkarak iyi uygulama örneklerini İzmir’e taşımayı hedeflemekteyiz. Aynı zamanda kendi tecrübelerimizi de küresel diğer kuruluşlar ile paylaşarak İzmir Metro AŞ’yi bir dünya markası haline getirmek için çalışmalarımıza devam edeceğiz” diye konuştu.
İzmir
Yayınlanma: 13 Temmuz 2025 - 20:32
İzmir Metro'ya uluslararası görev
İzmir Metro’ya uluslararası görev
İzmir
13 Temmuz 2025 - 20:32